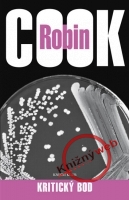

Knihy od autora Robin Cook
 Lekár a spisovateľ Robin Cook (1940) získal celosvetové uznanie trilermi s lekárskou tematikou, dnes už ich je viac ako štyridsať, z ktorých sa predalo vyše sto miliónov výtlačkov. Majstrovsky spája medicínske fakty s fantáziou, pričom verejnosť upozorňuje na technické možnosti modernej medicíny a z toho vyplývajúce etické otázky.
Lekár a spisovateľ Robin Cook (1940) získal celosvetové uznanie trilermi s lekárskou tematikou, dnes už ich je viac ako štyridsať, z ktorých sa predalo vyše sto miliónov výtlačkov. Majstrovsky spája medicínske fakty s fantáziou, pričom verejnosť upozorňuje na technické možnosti modernej medicíny a z toho vyplývajúce etické otázky.Striedavo žije na Floride a v Bostone.
Vo vydavateľstve IKAR od Robina Cooka vyšlo:
MUTÁCIA
NÁKAZA
KÓMA
EPIDÉMIA
CHROMOZÓM 6
INVÁZIA Z GALAXIE
TOXÍN
ÚNOSNÉ RIZIKO
INFEKCIA
ÚNOS
ŠOK
ZÁCHVAT
OSUDNÝ GÉN
KRÍZA
KRITICKÝ STAV
AGÓNIA
INTERVENCIA
LIEK
VÝNOSNÁ SMRŤ
NANO
VRAŽDA NA DIAĽKU
HOSTITEĽ
ŠARLATÁNI
PANDÉMIA
GENÉZA
VÍRUS
NOČNÁ SLUŽBA
SPOSOB SMRTI
Zobrazujem: 41 až 80 z 86
-
Léčba
Knižní klub, 2011Nie je na sklade -
Šok, 2. vydanie
IKAR, 2011Nie je na sklade -
Blízký konec
Knižní klub, 2011Nie je na sklade -
Deformace - 2. vydání
Knižní klub, 2011Nie je na sklade -
Epidémia, 3. vydanie
IKAR, 2010Nie je na sklade -
Intervencia
IKAR, 2010Nie je na sklade -
Osudný gén, 2. vydanie
IKAR, 2010Nie je na sklade -
Mutace - 2. vydání
Knižní klub, 2010Nie je na sklade -
Kritický bod
Knižní klub, 2010Nie je na sklade -
Epidemie - 3 . vydanie
Knižní klub, 2010Nie je na sklade -
Záchvat, 2. vydanie
IKAR, 2009Nie je na sklade -
Agónia
IKAR, 2009Nie je na sklade -
Únos, 2. vydanie
IKAR, 2009Nie je na sklade -
Záchvat CZ - 2.vydání
Knižní klub, 2009Nie je na sklade -
Invaze z galaxie - 2. vydání
Knižní klub, 2009Nie je na sklade -
Chromozom 6 - 2.vydání
Knižní klub, 2009Nie je na sklade -
Smrtelný strach - 2.vydání
Knižní klub, 2008Nie je na sklade -
Toxín, 2. vydanie
IKAR, 2008Nie je na sklade -
Kritický stav
IKAR, 2008Nie je na sklade -
Únosné riziko, 2.vydanie
IKAR, 2008Nie je na sklade -
Kóma - 2.vydanie
IKAR, 2007Nie je na sklade -
Kríza
IKAR, 2007Nie je na sklade -
Blízky koniec - 2.vydanie
IKAR, 2007Nie je na sklade -
Deformácia, 3.vydanie
IKAR, 2007Nie je na sklade -
Infekce - 2. vydání
Knižní klub, 2007Nie je na sklade -
Horečka - 2. vydání
Knižní klub, 2007Nie je na sklade -
Osudná liečba, 2.vydanie
IKAR, 2007Nie je na sklade -
Známky života - 2. vydání
Knižní klub, 2007Nie je na sklade -
Smrtící gen
Knižní klub, 2007Nie je na sklade -
Mozek - 3.vydání
Knižní klub, 2007Nie je na sklade -
Infekce - 3. vydání
Knižní klub, 2006Nie je na sklade -
Osudná léčba 2.vydání
Knižní klub, 2006Nie je na sklade -
Osudný gén
IKAR, 2006Nie je na sklade -
Toxin - 2. vydání
Knižní klub, 2006Nie je na sklade -
Únosné riziko - 3. vyd.
Knižní klub, 2006Nie je na sklade -
Deformace - 3.vydání
Knižní klub, 2005Nie je na sklade -
Epidémia - 2. vydanie
IKAR, 2005Nie je na sklade -
Invázia z galaxie - 2.vydanie
IKAR, 2005Nie je na sklade -
Sfinga - 2. vydání
Knižní klub, 2005Nie je na sklade -
Stážista - 2. vydání
Knižní klub, 2005Nie je na sklade
Výber žánrov
Beletria pre dospelých
- Biografické romány
- Dobrodružstvo, thrillery
- Historické romány
- Hobby - deti
- Horor
- Humor, satira
- Komiks
- Krimi, detektívky
- Ostatné - nezaradené
- Poézia
- Rodinné ságy
- Román pre ženy
- Romantika
- Sci-fi, fantasy
- Spoločenské romány
- Svetová klasika
- Svetová súčasná
- YOLi, young adult, new adult
Cestovanie, mapy
Česká literatúra
Deti do 10 rokov
Deti nad 10 rokov
Fond na podporu umenia
Jazyky, vzdelanie
Literatúra faktu
Odborná literatúra
Populárne náučná pre dospelých
- Erotika, sex
- Ezoterika, duchovné náuky
- Fauna, chovateľstvo
- Flóra, záhrada
- Hobby - muži
- Hobby - ženy
- Krása, móda, kozmetika
- Krížovky, hádanky, hry
- Kultúra, umenie
- Lexikóny,encyklopédie
- Literatúra faktu
- Medicína, zdravie
- Obrazové publikácie
- Partnerské vzťahy, rodina
- Právo, sociológia
- Šport & hry
- Varenie, nápoje, diéty
- Veda a technika
- Záhady, tajomno
- Zdravý spôsob života
- Životná pomoc, psychológia
- Životné prostredie, príroda
Slovenská literatúra
Darčekové predmety a ostatné
- Angličtina (tituly v Anglickom jazyku)
- Darčekové predmety
- Diáre
- Ezoterické predmety
- Hračky
- Hry ostatné
- Hry spoločenské
- Hry vzdelávacie, náučné
- Kalendáre
- Karty
- Kreativita
- Kuchyňa, domácnosť, záhrada
- Magnetky
- Omaľovánky
- Papiernický tovar
- Pexesá
- Puzzle
- Razítka, pečiatky
- Rôzny tovar
- Samolepky
- Školské diáre
- Učebnice
- Výtvarné potreby
- Záložky
- Zdravie, starostlivosť o telo
Hovorené slovo
Hudobné CD
- Domáci rock&pop
- Etno, jazz
- Film, muzikál
- Folk & country
- Klasická hudba
- Ľudové piesne
- Oldies
- Pesničky pre deti
- Relaxačná hudba
- Vianočná hudba
- Zahraničný rock&pop